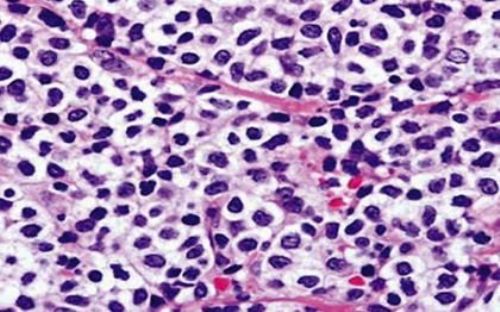
plazmocit2 plazmocit2

Плазмоцитома кожи – это доброкачественная опухоль кожи. Она состоит из клеток плазмы. При развитии не затрагивает костный мозг и другие органы, но может перейти в злокачественное новообразование.
Может стать причиной изменений специфического или неспецифического характера.
Специфические изменения – это:
- первичные поражения (образуются на коже. Клинически протекают благоприятно);
- вторичные поражения (развиваются из-за того, что процесс распространяется на внутренние органы или кости).
Заболевание проявляет сложным набором симптомов, которые заключаются в:
- медуллярных проявлениях (костный, оссальгический);
- экстрамедуллярный (анемический, почечный, кожный, нервный, амилоидный, гепатоспленомегалический);
- смешанный (медуллярно-экстрамедуллярный).
Клинически оба типа протекают одинаково.
Первичные виды развиваются очень редко. В этом случае у больных на коже появлялись образования опухолевого типа, которые имели сине-красную или буро-синюю окраску. Они располагаются изолированно и очень редко сливались друг с другом.
Плазмоцитомы обычно располагаются на волосистой части головы, верхней половине груди, лице и руках. Она может дать метастазы в висцеральные органы или лимфатические узлы.
Первичный тип характерен тем, что на коже образуются множественные или одиночные очаги, которые выглядят как инфильтрованные бляшки с четкими круглыми контурами. По размерам они могут достигать 1-5 см. во временем опухоль становится больше и имеет более плотную узловатую форму с плотноэластической консистенцией.
Вторичный тип встречается чаще. Они образуются на теле или конечностях. Опухоль по размерам достигает размеров голубиного яйца. Образования имеют плотно-эластичную или мягкую консистенцию. Имеют бурый оттенок и синюшно-красный цвет.
Они образуются на 2 стадии опухолевого процесса, примерно через 2-2,5 года после начала развития множественной миеломы. На коже развиваются сразу несколько очагов поражения.
Боли не проявляются. Из-за некротического распада элементов опухоли образуются язвы, которые отличаются кровянисто-гнойным отделяемым.
Клинически они проявляются бляшками или узелками, которые отличаются язвенными или некротическими изменениями.
Токсические проявления на коже характерны появлением эритематозно-отечных пятен, пигментацией кожи, себорейно-подобными изменениями и т.п. из-за изменений состава крови возникают пурпуры, экхимозы, лейкопения и т.п.
Если поражены почки может развиться отек кожи, который вызывает сильный зуд. Если опухоль растет на нервных ганглиях, может развиться опоясывающий лишай.
Неспецифичные высыпания диагностируют чаще, чем специфичные.
Они образуются из-за нарушения процесса обмена белков, и интоксикации организма продуктами метаболизма.
Причиной таких проявлений называют отложения амилоида в коже.
Диагностика
Диагностика основывается на гистологических анализах, которые должны стать подтверждение развития опухолевого процесса.
Плазмоцитомы кожи представляют собой редкую форму опухолей, возникающих из плазматических клеток. Врачи отмечают, что различают два основных типа: первичные, возникающие в коже, и вторичные, развивающиеся на фоне системных заболеваний, таких как множественная миелома. Диагностика этих образований требует комплексного подхода, включая клинический осмотр, биопсию и гистологическое исследование. Врачи подчеркивают важность раннего выявления, так как это значительно улучшает прогноз. Лечение плазмоцитомы кожи может включать хирургическое удаление, радиотерапию и химиотерапию, в зависимости от стадии заболевания и общего состояния пациента. Специалисты рекомендуют регулярные обследования для мониторинга состояния и предотвращения рецидивов.

Лечение
Лечение заключается в использовании цитостатических лекарств, а также кортикостероидов, анаболитических средств и лучевой терапии. Маленькие очаги иногда удаляют хирургическим путем. При первичной форме используют монохимиотерапию
Плазмоцитомы кожи — редкое, но серьезное заболевание, которое вызывает много вопросов у пациентов и врачей. Люди часто делятся своими переживаниями о диагностике, которая может быть сложной из-за схожести симптомов с другими кожными заболеваниями. Важно, чтобы врачи проводили тщательное обследование, включая биопсию, чтобы подтвердить диагноз.
Многие пациенты отмечают, что ранняя диагностика значительно улучшает прогноз, поэтому они призывают не игнорировать первые симптомы. Лечение плазмоцитомы кожи обычно включает химиотерапию и радиотерапию, однако подходы могут варьироваться в зависимости от стадии заболевания. Пациенты делятся опытом о том, как важно иметь поддержку близких и общаться с теми, кто прошел через подобные испытания. Это помогает не только морально, но и дает полезные советы по лечению и восстановлению.
Прогноз
Это заболевание очень опасно и часто приводит к смерти из-за анемии, пневмонии, кахексии.
Если плазмоцитома кожи дает метастазы в костный мозг, человек может прожить примерно 1,5 года. Если метастазов нет, срок жизни составляет примерно 10 лет.

Вопрос-ответ
Как лечат плазмоцитому?
Лечение Солитарная плазмоцитома практически не поддается химиотерапии, поэтому ее облучают или удаляют хирургически. Это хорошо действует примерно в 50% случаев. Если операция не помогла остановить болезнь, то у больного в течение двух-трех лет обычно развивается множественная миелома.

Как лечить кожный плазмоцитоз?
Другие доступные местные методы лечения кожного плазмоцитоза включают радиотерапию, фотодинамическую терапию и псорален в сочетании с ультрафиолетом А (16).
Сколько живут с плазмоцитома?
В последние годы наблюдается существенный прогресс в области исследований миеломы и плазмоцитомы. Это способствует тому, что прогноз для пациентов с данным заболеванием значительно улучшился. Средний срок выживаемости пациентов с плазмоцитомой составляет 5 лет. Эффективность лечения зависит от многих факторов.
Что такое экстрамедуллярная плазмоцитома?
Плазмоцитома экстрамедуллярная (взрослые, стационар)- Злокачественная опухоль, состоящая из плазматических клеток, которые растут в пределах осевого скелета или в мягких тканях – носит название плазмоцитома (гемобластоз).
Советы
СОВЕТ №1
Обратите внимание на любые изменения на коже, такие как новые образования или изменения в существующих родинках. Регулярно проводите самообследование и при обнаружении подозрительных участков обращайтесь к дерматологу для консультации.
СОВЕТ №2
Если у вас уже диагностирована плазмоцитомы кожи, следуйте рекомендациям вашего врача и не пропускайте запланированные контрольные обследования. Это поможет отслеживать динамику заболевания и своевременно корректировать лечение.
СОВЕТ №3
Изучите доступные методы лечения плазмоцитомы, включая как традиционные, так и альтернативные подходы. Обсудите с врачом возможность участия в клинических испытаниях, которые могут предложить новые варианты терапии.
СОВЕТ №4
Поддерживайте здоровый образ жизни, включая сбалансированное питание и регулярные физические нагрузки. Это может помочь укрепить иммунную систему и улучшить общее состояние здоровья, что важно при любом онкологическом заболевании.